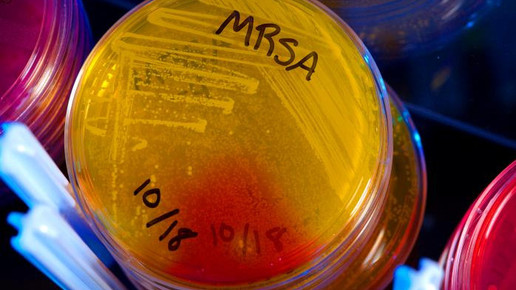
Staphylococcus aureus MRSA cdc james gathany

Apothekerin senkt Antibiotika-Verbrauch
Während der weltweite Antibiotika-Verbrauch weiter steigt, geht das Universitätsklinikum Dresden seit gut drei Jahren konsequent den entgegengesetzten Weg. Es werden dort nach strengen Kriterien nur noch dann Antibiotika eingesetzt, wenn dies nötig ist. Das zahlt sich auch finanziell aus: Dieses Monitoring hat dem Klinikum im vergangenen Jahr Einsparungen von etwa 1 Million Euro gebracht, was rund 20 Prozent der Gesamtausgaben für Antiinfektiva entspricht.
Den Anstoß zum Antibiotika-Monitoring gab Katja de With, Leiterin der Klinischen Infektiologie am Uniklinikum Dresden, mit ihrer 2013 gestarteten Initiative. Dazu gehört seitdem die mehrmals jährlich stattfindende Ärzteschulung über den indikationsgerechten Einsatz von Antiinfektiva.
Darüberhinaus wird auf den Intensivstationen der Antibiotikaeinsatz bei jedem Patienten besprochen und kritisch hinterfragt. Bestätigt sich die vermutete Infektionsdiagnose nicht, wird die Therapie beendet. Eine Aufschlüsselung nach Indikationen, bei denen die Antibiotikavergabe nach den neuen Kriterien am auffallendsten gesunken ist, macht die Klinik nicht. Aber die Ärzte müssen jede einzelne Gabe begründen und unterschreiben.
Insgesamt hat das Vorgehen zu einem deutlichen Rückgang im Gesamtverbrauch geführt und gleichzeitig auch zu einem deutlich erhöhten Einsatz von Schmalspektrum- anstelle von Breitspektrum-Antibiotika. Darüber hinaus wurde für Reserve-Antibiotika eine Sonderrezeptregelung erlassen, sodass diese Substanzen nur in begründeten Fällen eingesetzt werden, was bei Infektionen mit resistenten Erregern der Fall ist.
De With, die Apothekerin, Internistin und Infektiologin ist, koordiniert die ABS Fortbildungsinitiative der Deutschen Gesellschaft für Infektiologie (DGI), verantwortet als Erstautorin die Leitlinie „Strategien zur Sicherung rationaler Antibiotika-Anwendung im Krankenhaus” und ist an dem deutschlandweiten Projekt Antibiotika-Verbrauchssurveillance der DGI beteiligt.
Rund eine halbe Million Menschen infizieren sich nach Angaben des Nationalen Referenzzentrums (NRZ) jedes Jahr in deutschen Kliniken mit bakteriellen Erkrankungen. Zwischen 10.000 und 15.000 von ihnen sterben. Bei den multiresistenten Erregern (MRSA) schlagen bereits etliche Antibiotika nicht mehr an. MRSA kann Hautentzündungen wie Geschwüre, Wundinfektionen und Entzündungen einzelner Organe verursachen.
Während in Griechenland jeder zweite und in den Niederlanden jeder dritte Krankenhauspatient Antibiotika bekommt, ist Deutschland mit einer durchschnittlichen Abgabe an jeden vierten Krankenhauspatienten im guten Mittelfeld. Aber der Fall aus Dresden zeigt: Es geht auch mit noch weniger.

APOTHEKE ADHOC Debatte